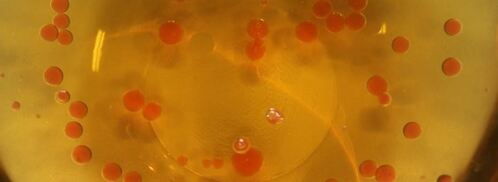
мусс из куриной печенки с икрой из морса. Шаг 7

Любите готовить мусс? Попробуйте рецепт мусса апельсинового. Должно понравиться.
1. Заранее ставим в холодильник оливковое масло. Разогреваем сотейник с добавлением оливкового масла. Выкладываем морковь и лук. Обжариваем до золотистого цвета. Добавляем измельченные зубчики чеснока. Вливаем коньяк. Фламбируем.
2. Добавляем куриную печень. Обжариваем в течение трех минут. Все время помешиваем. Посолим и поперчим.

3. Вливаем сливки в печенку. Доводим до консистенции сметаны. Посолим. Измельчаем блендером.

4. Готовим икру. Вливаем в отдельный сотейник морс. Добавляем агар-агар. Перемешиваем. Нагреваем.

5. Наливаем в миску охлажденное оливковое масло. Как только начнет закипать морс, снимаем с огня. Кладем куриный мусс в банку. Украшаем базиликом.

6. Добавляем еще немного агар-агара в морс. Набираем морс в шприц. Капаем в охлажденное масло.
7. Откидываем икру через сито. Выкладываем на куриный мусс. Приятного аппетита!

Главное не опускать руки, тогда всё получится. Рекомендую земляничный мусс. Должно быть вкусно. Чаще готовьте новые блюда, нужно быть в форме! Всегда стараюсь приготовить что-нибудь новое.
Комментарии к рецепту
Ммм…Наслаждение!
Оценили все!
Я тоже очень люблю ваш сайт.
подробнее и доступнее просто не придумать)))
мне кажется даже человек никогда не готовивший раньше -сможет без проблем освоиться по вашему сайту с кулинарией!)))
Сделала, как написано, впервые!
и получилось обалденно вкусно)
Получилось «ужасно» вкусно!!!:)
Danke sehr!!!
recpty.ru/deserty/muss/muss-iz-tykvy готовила, а вот мусс из куриной печенки с икрой из морса - никогда. Надо попробовать. Спасибо за рецепт.
МНЯ-МНЯ! ОЧЕНЬ ВКУСНО!
Большое спасибо!
рецепт пришелся по вкусу
Очень просто, доступно и аппетитно. Порадовало пошаговое объяснение.